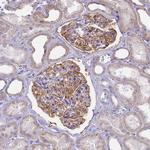
CD35 Antibody in Immunohistochemistry (Paraffin) (IHC (P))

Search
Invitrogen
CD35 Polyclonal Antibody
{{$productOrderCtrl.translations['antibody.pdp.commerceCard.promotion.promotions']}}
{{$productOrderCtrl.translations['antibody.pdp.commerceCard.promotion.viewpromo']}}
{{$productOrderCtrl.translations['antibody.pdp.commerceCard.promotion.promocode']}}: {{promo.promoCode}} {{promo.promoTitle}} {{promo.promoDescription}}. {{$productOrderCtrl.translations['antibody.pdp.commerceCard.promotion.learnmore']}}

Please note: We are reviewing Western blot images included in the antibody testing data in our catalog, including those provided by third parties. Unless expressly labeled or annotated as “raw-unedited”, Western blot images included in the antibody testing data in our catalog may have been edited, optimized or otherwise adjusted for presentation.
产品信息
PA5-83616
种属反应
宿主/亚型
分类
类型
抗原
偶联物
形式
浓度
规格
纯化类型
保存液
内含物
保存条件
运输条件
RRID
产品详细信息
Immunogen sequence: LIGSPSTTCL VSGNNVTWDK KAPICEIISC EPPPTISNGD FYSNNRTSFH NGTVVTYQCH TGPDGEQ
Highest antigen sequence indentity to the following orthologs: Mouse - 61%, Rat - 58%.
靶标信息
CD35 (CR1, Complement Receptor 1) is a cell membrane-bound, monomeric glycoprotein and its primary function is to serve as the cellular receptor for C3b and C4b, the most important components of the complement system leading to clearance of foreign macromolecules. CD35 protein mediates cellular binding to particles and immune complexes that have activated complement. The CD35 complex is four different allotypes (C,A,B,D) C is 160 kDa; A is 190 kDa; B is 220 kDa and D is 250 kDa. CD35 is involved in the processing of immune complexes, promoting of binding and phagocytosis of C3b complexes and inhibition of complement activation. CD35 is on neutrophils, eosinophils, monocytes, B-cells, some NK-cells, erythrocytes, myeloid leukemias, follicular dendritic reticulum cells and is negative on basophils. Decreases in expression of CD35 protein and/or mutations in its gene have been associated with gallbladder carcinomas, mesangiocapillary glomerulonephritis, systemic lupus erythematosus and sarcoidosis. Mutations in the CD35 gene have also been associated with a reduction in Plasmodium falciparum rosetting, conferring protection against severe malaria. Alternate allele-specific splice variants encoding different isoforms of CD35 have been characterized. An additional secreted form of CD35 have also been described but has not been fully characterized.
仅用于科研。不用于诊断过程。未经明确授权不得转售。
篇参考文献 (0)
生物信息学
蛋白别名: C3 binding protein; C3b/C4b receptor; CD35; Complement Component (3b/4b) receptor 1 including Knops blood group system; Complement receptor type 1
基因别名: C3BR; CR1
Entrez Gene ID: (Human) 1378




